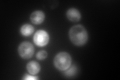

View description
Triose phosphate isomerase, abundant glycolytic enzyme; mRNA half-life is regulated by iron availability; transcription is controlled by activators Reb1p, Gcr1p, and Rap1p through binding sites in the 5' non-coding region
Localization:
Intensity:
Fold change:
Significance:
-
C’ GFP library in SD

cytosol1013.75 -
N' NOP1pr-GFP in SD

cytosol501.909 -
N' TEF2pr-mCherry in SD

cytosol588.648 -
N' NATIVEpr-GFP in SD

cytosol948.535 -
N' TEF2pr-VC and Cyto-VN in SD

#N/A0 -
C’ GFP library in SD+DTT

cytosol982.340.96No -
C’ GFP library in SD+H2O2

cytosol969.30.95No -
C’ GFP library in Starvation Media
cytosol917.240.9No -
C’ GFP library on the background of Pup2-DaMP

cytosol -
C’ GFP library on the background of CCT mutant

cytosol826.1460.814936No
